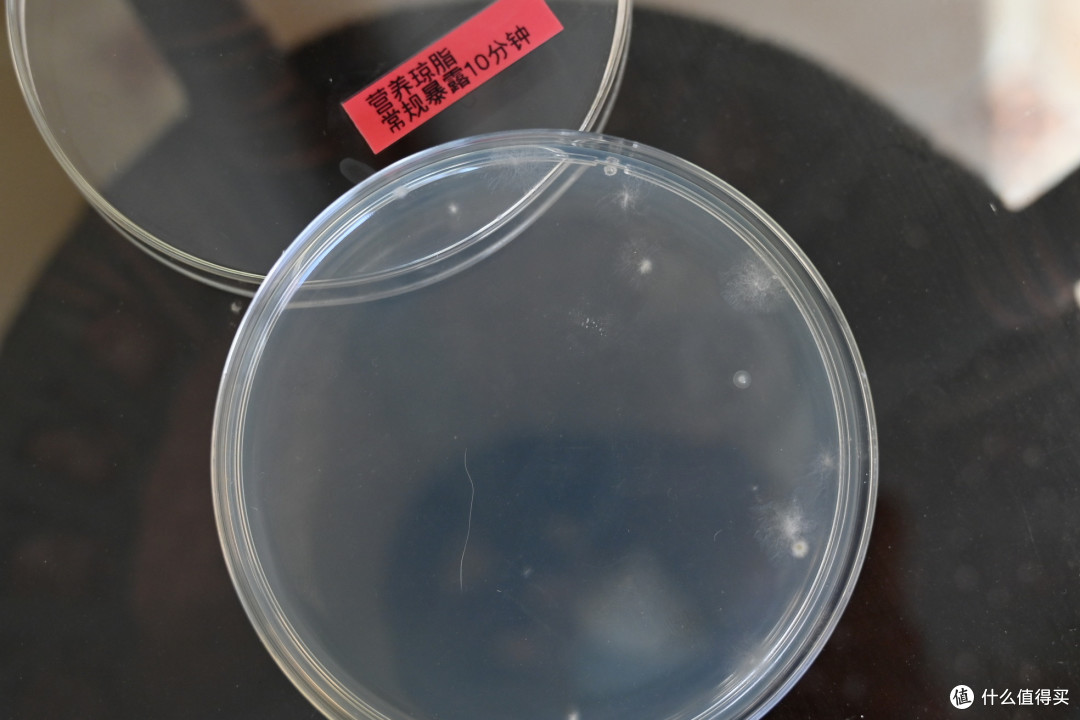
aoe空气消毒机到底怎么样?"疫"军突起之时,它为家人保驾护航

乳酸盐

小样乳酸盐《燃烧吧少年!》 李宇春教"小面瘫"控制表情
图片尺寸518x304
小样乳酸盐
图片尺寸790x1034
贝贝哩宝宝南瓜味乳酸菌调味盐
图片尺寸1080x1439
分享辅食盐啦让宝宝很爱ohsaucy乳酸菌盐
图片尺寸1080x1080
广州百特 腹膜透析液(乳酸盐-g4.25%)
图片尺寸700x589
低钙腹膜透析液(乳酸盐-g1.5%)(百特腹透液)
图片尺寸525x477
腹膜透析液(乳酸盐)的性状
图片尺寸526x472
樱印原装进口低钠调味盐调味品乳酸菌调味料 乳酸菌调味盐 蘑菇乳酸菌
图片尺寸800x800
宝宝调味盐我选贝贝哩南瓜味乳酸菌调味盐
图片尺寸1080x1439
低钙腹膜透析液(乳酸盐-g4.25%)
图片尺寸5184x3456
低钙腹膜透析液(乳酸盐-g1.5%)
图片尺寸900x675
腹膜透析液(乳酸盐-g2.5%)
图片尺寸900x675
腹膜透析液乳酸盐
图片尺寸446x644
广州百特 腹膜透析液(乳酸盐-g1.5%)
图片尺寸700x662
食品级乳酸钠
图片尺寸1080x1443
腹膜透析液(乳酸盐-g4.25%)
图片尺寸900x675
ohsaucy乳酸菌蔬菜调味盐100g
图片尺寸730x1235
2024年乳酸盐利好什么上市公司a股乳酸盐这两只股票值得关注
图片尺寸750x400
乳酸盐含量的测定
图片尺寸550x381
aoe空气消毒机到底怎么样?"疫"军突起之时,它为家人保驾护航
图片尺寸1080x720